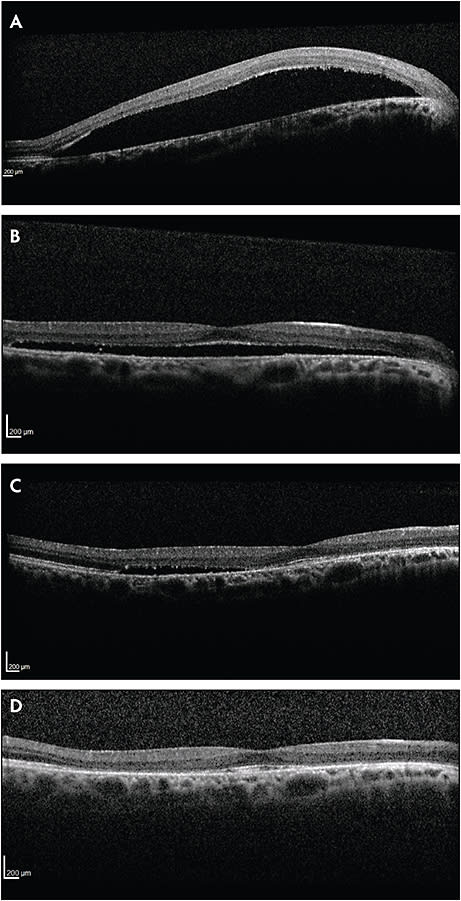

Treatment of Optic Disk Pit Maculopathy
Several surgical options exist.
STEVEN R.J. LAPERE, MBChB, FRCOphth • JASPREET S. RAYAT, MD • MATTHEW T.S. TENNANT, MD, FRCSC
An optic disk pit (ODP) is a congenital round or oval depression in the optic disk. ODPs are usually unilateral, with an equal gender predilection and an incidence of one in 11,000.1 They are most commonly found at the inferotemporal aspect of the disk, but they may also be found elsewhere, including centrally.2
In isolation, ODPs are often asymptomatic; however, they may go on to develop an associated neurosensory detachment of the macula (Figure 1), with subsequent reduction in vision. This maculopathy occurs in 25% to 75% of patients with ODPs,3,4 and it usually occurs in the third to fourth decade of life.5

Figure 1. Images of a patient with optic disk pit maculopathy. The pit size may be from one-eighth to half the diameter of the optic disk. There is a neurosensory detachment of the fovea.
When ODP maculopathy is present, visual acuity is usually reduced to 20/70 or worse.1 Although spontaneous resolution has been reported in some cases,6 the majority of cases have a poor prognosis, with a natural history of gradual worsening and final VA of 20/200 or worse.7
ANATOMIC CONSIDERATIONS
The etiology of the subretinal and intraretinal fluid associated with ODP maculopathy remains controversial, with several possible sources being proposed. The first and most likely source of the fluid is the vitreous.
It is postulated that vitreous traction on the retina, underlying the area of Martegiani and the bursa premacularis, leads to the development of a negative pressure gradient that draws fluid in through the optic pit and into the submacular space.
Steven R.J. Lapere, MBChB, FRCOphth, Jaspreet S. Rayat, MD, and Matthew T.S. Tennant, MD, FRCSC, practice with the Department of Ophthalmology of the University of Alberta in Edmonton, Canada. None of the authors reports any financial interests in products mentioned in this article. Dr. Lapere can be reached via e-mail at steven.lapere@gmail.com.
This theory is supported by spontaneous resolution of fluid with the development of a posterior vitreous detachment and by the evidence of a direct connection between the subretinal space of the macula and the ODP on optical coherence tomography (Figure 2).

Figure 2. ODP maculopathy. Note the connection between the subretinal space and ODP on optical coherence tomography.
Further support can be found at the time of surgery, when schlering is aspirated through the ODP with immediate resolution of the maculopathy. Finally, there have been several studies that have reported on the passage of gas or silicone oil from the vitreous cavity to the subretinal space in eyes, with cavitary anomalies of the optic disk, including ODP.7-9
Historically, cerebrospinal fluid has been proposed to enter the intra- and subretinal space from the subarachnoid space through the ODP defect. A study by Kalina et al did not demonstrate a connection between the subarachnoid and subretinal spaces.10
Leakage from peripapillary blood vessels adjacent to the ODP or from the choroidal vasculature has been suggested as a source for subretinal and intraretinal fluid associated with the maculopathy.
This hypothesis is less likely because not all eyes with ODP and sensory macular detachment demonstrate late hyperfluorescence at the disk with fluorescein angiography.4 In addition, there are other conditions that cause significant chorioretinal atrophy in which subretinal fluid is not observed.11
MANAGEMENT OPTIONS
At this time, there is little consensus in the medical literature regarding best practices for the repair of ODP maculopathy. Multiple surgical options are available; however, it remains unclear regarding the combination of procedures that maximizes surgical success while minimizing side effects and possible complications.

Figure 3. ODP maculopathy is a neurosensory detachment that can often be associated with a macular schisis. Top) Neurosensory detachment only. Bottom) Combined neurosensory detachment with a schisis.
Laser Photocoagulation
Laser photocoagulation at the temporal disk margin has been proposed as a treatment for ODP maculopathy.12 The suggested rationale is that the laser scars will act as a barrier between the ODP and the subretinal space.
This method of treatment, when performed in isolation, has largely fallen out of favor, because the time for improvement is variable and often long, and the location of the laser treatment over the maculopapular bundle can cause significant visual field defects.13
Intravitreal Gas Tamponade
Intravitreal gas injection without adjuvant therapy has been attempted in three case series of eight eyes or fewer.14-16 The rationale for this treatment is that pneumatic displacement may cause a PVD while sealing the optic nerve pit, thereby allowing reattachment of the macula. Gas injection alone resulted in a 50% reattachment rate, but more than one injection was often necessary. When combined with photocoagulation, the success rate was higher.17
Macular Buckle
Macular buckling surgery to treat ODP has been proposed as an alternative approach.18 This technique has been reported to resolve subretinal fluid in 85% of cases, but it has not gained popularity since its introduction 20 years ago, and all reports of results have come from the same group.
Pars Plana Vitrectomy
Pars plana vitrectomy has become the treatment of choice for ODP maculopathy. It has been proposed that induction of a complete PVD during surgery is essential for achieving macular reattachment by relieving the traction.19 The necessity of adjuvant surgical procedures remains unclear, but they include temporal ODP endolaser, internal limiting membrane peeling, and/or gas tamponade.
Endolaser therapy at the time of vitrectomy on the temporal aspect of the optic nerve through the papillomacular bundle is commonly performed at many centers in an effort to maximize surgical success. It carries with it a significant risk of visual field defect and vision loss.20,21
Figure 4. A) Preoperative OCT of right eye revealing subretinal fluid. B) Same patient one month postoperatively with decreased amount of subretinal fluid. C) Same eye seen six months postoperatively showing further diminishing of the subretinal fluid. D) Fifteen-month follow-up with complete macular reattachment.
Internal limiting membrane peeling has been suggested to be an important component of surgical treatment for ODP maculopathy.20 However, good results have been reported without ILM peeling, and some authors believe it is not required.21
Gas tamponade in combination with vitrectomy has been hypothesized to seal the ODP, displace the macular subretinal fluid to the extramacular space, and stimulate the retinal pigment epithelium to pump out fluid.22
RECENT EVIDENCE
In 2015, Rayat et al published a retrospective, multicenter trial that assessed surgical success utilizing a variety of techniques for ODP maculopathy.23 Thirty-two eyes were included in the final analysis. All of the eyes underwent PPV with triamcinolone-confirmed PVD with or without adjuvant treatments (gas tamponade and/or ILM peeling and/or temporal endolaser).
Foveal reattachment occurred in 81% of eyes postsurgery at a median time of 416 days. Ten of 34 eyes required reoperation, and the average time to the second surgery was 404 days. VA improved from a mean preoperative level of 20/185 to a final VA of 20/63. Success rates were not affected by ILM peeling, temporal laser at the disk margin, or type of gas utilized (air, SF6 or C3F8).23
These results suggest that laser and ILM peeling may be unnecessary for patients with ODP maculopathy. Surgeons should consider the potentially harmful effects of laser at the disk margin, as well as ILM peeling.
Complete separation of the vitreous from the optic nerve and macula appears to be of primary importance for surgical success with no improvement in success when using adjuvant therapies (laser, ILM peeling, and/or gas tamponade).
The authors recommend triamcinolone staining of the vitreous to confirm complete separation from the retina and identification of any residual vitreous. Removal of this traction by vitrectomy and surgically induced PVD allows the RPE pump to reabsorb subretinal fluid, reattaching the retina and thereby improving VA.
The results of the upcoming and much larger European retrospective trial on ONP maculopathy should provide additional insight regarding the surgical procedures that have the highest success rates.
CONCLUSION
Optic disk pit maculopathy cases are challenging to manage. Current evidence suggests that the subretinal fluid associated with the maculopathy is most likely vitreous in origin. There are no established guidelines for the treatment of ODP maculopathy; however, PPV with triamcinolone-assisted PVD is an effective technique to reattach the retina.
Peripapillary endolaser, ILM peeling, and/or gas tamponade may be unnecessary, and it does not appear to improve the rate of retinal reattachment. Submacular fluid is slow to resolve postvitrectomy, and foveal reattachment may take longer than one year. RP
REFERENCES
1. Georgalas I, Ladas I, Georgopoulos, Petrou P. Optic disc pit: a review. Graefes Arch Clin Exp Ophthalmol. 2011;249:1113-1122.
2. Theodossiadis GP, Panopouls M, Kollia AK, Georgopoulos G. Long-term study of patients with congenital pit of the optic nerve and persistent macular detachment. Acta Ophthalmol. 1992;70:495-505.
3. Brown GC, Shields JA, Goldberg RE. Congenital pits of the optic nerve head. II. Clinical studies in humans. Ophthalmology. 1980;87:51-65.
4. Bonnet M. Serous macular detachment associated with optic nerve pits. Graefes Arch Clin Exp Ophthalmol. 1991;229:526-532.
5. Brodsky MC. Congenital optic disk anomalies. Surv Ophthalmol. 1994;39:89-112.
6. Efstratios AP, Irini PC, Vasileisos GP. Spontaneous resolution of long-standing macular detachment due to optic disc pit with significant visual improvement. Case Rep Ophthalmol. 2014;5:104-110.
7. Sobol WM, Blodi CF, Folk JC, Weingeist TA. Long-term visual outcome in patients with optic nerve pit and serous retinal detachment of the macula. Ophthalmology. 1990;97:1539-1542.
8. Dithmar S, Schuett F, Voelcker HE, Holz FG. Delayed sequential occurrence of perfluorodecalin and silicone oil in the subretinal space following retinal detachment surgery in the presence of an optic disc pit. Arch Ophthalmol. 2004;122:409-411.
9. Salam A, Khan-Lim D, Lu AJ. Superior retinal detachment in an oil filled eye with a colobomatous optic disc. Retina Cases Brief Rep. 2008;2:124-125.
10. Coll GE, Chang S, Flynn TE, Brown GC. Communication between the subretinal space and the vitreous cavity in the morning glory syndrome. Graefes Arch Clin Exp Ophthalmol. 1995;233:441-443.
11. Kalina RE, Conrad WC. Intrathecal fluorescein for serous macular detachment. Arch Ophthalmol. 1976;94:1421.
12. Sadun AA, Khaderi KH. Optic disc anomalies, pits, and associated serous macular detachment. In: Retina, 5th ed. London, UK; Elsevier Health Sciences, 2013:1583-1588.
13. Gass JD. Serous detachment of the macula. Secondary to congenital pit of the optic nervehead. Am J Ophthalmol. 1969;67:821-841.
14. Reed D. Congenital pits of the optic nerve. Clin Eye Vis Care. 1999;11:75-80.
15. Linco H, Kreissig I. Optical coherence tomography of pneumatic displacement of optic disc pit maculopathy. Br J Ophthalmol. 1998;82:367-372.
16. Akiyama H, Shimoda Y, Fukuchi M, et al. Intravitreal gas injection without vitrectomy for macular detachment associated with an optic disk pit. Retina. 2014;34:222-227.
17. Lei L, Li T, Ding X, Ma W, et al. Gas tamponade combined with laser photocoagulation therapy for congenital optic disc pit maculopathy. Eye (Lond). 2015;29:106-114.
18. Theodossiadis GP, Chatziralli IP, Theodossiadis PG. Macular buckling in optic disc pit maculopathy in association with the origin of macular elevation: 13-year mean postoperative results. Eur J Ophthalmol. 2015;25:241-248.
19. Bartz-Schmidt KU, Heimann K, Esser P. Vitrectomy for macular detachment associated with optic nerve pits. Int Ophthalmol. 1995;19:323-329.
20. Georgalas I, Petrou P, Koutsandrea C, Papaconstadinou D, Ladas I, Gotzaridis E. Optic disc pit maculopathy treated with vitrectomy, internal limiting membrane peeling, and gas tamponade: a report of two cases. Eur J Ophthalmol. 2009;19:324-326.
21. Avci R, Yilmaz S, Inan UU, et al. Long-term outcomes of pars plana vitrectomy without internal limiting membrane peeling for optic disc pit maculopathy. Eye (Lond). 2013;27:1359-1367.
22. Travassos AS, Regadas I, Alfaiate M, et al. Optic pit: novel surgical management of complicated cases. Retina. 2013;33:1708-1714.
23. Rayat JS, Rudnisky CJ, Waite C, et al. Long-term outcomes for optic disk pit maculopathy after vitrectomy. Retina. 2015;35:2011-2017.








